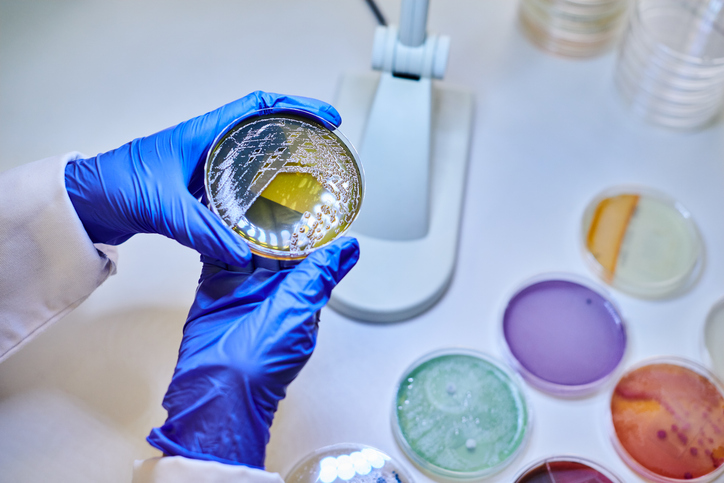

by Chris Warren
Non-tariff barriers are non-tax measures encountered during the importation of commodities. These are frequently encountered by the Partnership for Supply Chain Management (PFSCM) during importation processes.
Some of these contribute little to delays as their overall management is commonplace, routine, and relatively straightforward. Other non-tariff measures are less routine, difficult to address, and, if not innovatively and precisely managed, can have a tremendous impact on the amount of time it takes to clear commodities.
Non-tariff barriers always serve some purpose. For example, they support rules and regulations that ensure imported items correspond to national standards to protect the well-being of citizens. Sometimes their purpose may not be as readily apparent as this, and the layers of complexity impeding the import process can seem not only perplexing, but also counterproductive.
The presence of non-tariff barriers can also be frustrating to donors and implementing partners who are contributing to addressing the health needs of countries and would prefer to see the importation process sped up accordingly. However, as complex and time-consuming as it might be, non-tariff barriers are considered to be part of the procurement process and subsequently factored into lead times when they are known. The reasons for its existence can be divided into three categories.
Protecting domestic markets
National government authorities can set restrictions on importation for specific products in order to support established local producers or protect infant industries. When there is an established domestic health commodity industry supplying to the public sector, those industries may raise concerns that imported goods destabilize their markets. Non-tariff barriers may exist to support this perspective.
Protecting consumers
National health standards for determining the safety and effectiveness of health commodities are often established based on evaluations specific to an individual country’s needs. Though these may be different than those determined by donors or the manufacturer, they may still be completely valid. The basis for these differences may be various health needs that result from factors such as climate, geography, life expectancy, and disease patterns. Whatever the difference may be, these standards generally result in legislated rules and regulations to protect the citizenry from the risks associated with poor quality imports, such as could be experienced with expired, fake, substandard, or unregistered products.
Exercising sovereignty
Non-tariff barriers can also be a punitive response directed towards exporting countries that have implemented their own non-tariff barriers to imports from the recipient country. They may also be put in place as a response to disagreements in foreign policy objectives. Sometimes this kind of non-tariff barrier has nothing to do with the product being imported but rather with how it is imported, such as with airlines or trucking companies that are not nationally registered.
Examples of non-tariff barriers:
- Pre-inspection
- Import licenses and/or permits
- Automatic demurrage
- Assorted handling fees
- Packing, language, and marking requirements
- Trade documents
- Translation services
- Import deposits
- Administrative feeds
- Airline non-objections fees
The added value of PFSCM
PFSCM’s broad awareness of multiple iterations of importation processes, and cognizance of the fact that these can, and do frequently change, enables us to work with vendors and recipients to prepare documents before commodities are shipped, anticipate where new challenges may arise, and compress delivery delays or avoid them altogether.
System strengthening is also something that PFSCM does in this area. Through collecting and documenting the evidence of the impact of non-tariff barriers on behalf of public health programs, we enable the programs to advocate for national-level policy changes that will subsequently improve their supply chains. This could be something relatively straightforward as advocating for a distinction to be made between humanitarian shipments of health commodities and commercial shipments, or raising the awareness of public officials to the human cost and health impact of inefficient port and customs management.
PFSCM also supports recipients in increasing their understanding of their role in the importation process to ensure they have the capacity to handle the shipments. PFSCM works with the recipient’s staff to determine the specific customs procedures and documentation necessary to bring the shipment into their country.
On occasion we also work with the recipient to draft documents in the country’s official language in order to speed up the customs clearance process.
PFSCM’s experience with a wide supplier base further enables us to consult with suppliers to learn of their experiences as they are often familiar with the importing procedures for a number of countries.
Complementing this is PFSCM’s retention of experienced freight forwarders and logistics services providers who are familiar with the requirements for the importation of health care commodities on a country-by-country basis
Intervening in the importation of health care commodities, particularly in situations with multiple non-tariff barriers, is not a simple process, especially if relationships between staff from different ministries do not exist.
Further, Ministry of Health programs are often not enabled with the staff or the administrative authority to intervene with other government ministries such as ministries of finance, customs, transportation or pharmacy regulatory authorities.
PFSCM takes pride in aiding in bridging the experience gap between importation authorities and health program implementers to the point where the ability of the host government to manage importation is strengthened, while the needs of public health programs are simultaneously supported.